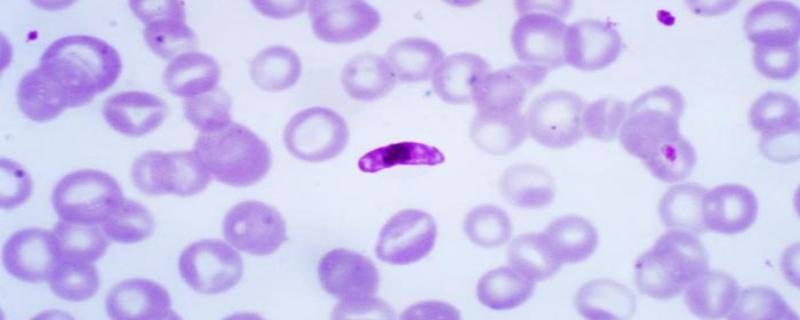
Study explores how blood parasites spread among birds in the Western Ghats

Sometime in the middle of October each year, the Bomrr clan in Nagaland rush to the caves in Mimi village. With a good stock of burning firewood, men and women are ready for the bat harvest festival—an annual ritual where anywhere between 7,000 to 25,000 bats are suffocated or smashed to their deaths. These bats, the clan believes, have medicinal properties and can cure diseases like diarrhoea and body ache, and increase vigour. Now, a new study has shown that these bats, rather than being a cure to diseases, carry deadly filoviruses that could infect humans.
IIT Bombay’s new deep learning framework, named SpADANet, enhances damage classification accuracy using limited labels across multiple hurricanes.
Mumbai/

![Participants of the annual bat harvest in Nagaland, India, counting and bundling bats, which will be distributed to male members of the Bomrr clan for consumption [Image credit: Dr Zavei Hiese] On the edge: Bats in northeast India found to carry filoviruses that could spread to humans](/sites/researchmatters/files/styles/large_front_800x320/public/bats.jpg?itok=p7IVXnxl)